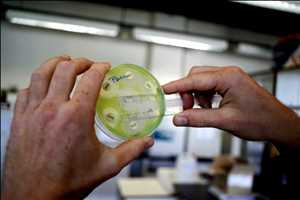
Tecnología de biología sintética Tendencias de crecimiento del mercado

El documento presentado Tecnología de biología sintética proporciona un análisis exhaustivo del mercado global de Tecnología de biología sintética . La primera sección del documento define la dinámica del mercado Tecnología de biología sintética y proporciona un modelo de nivel ejecutivo. Además del consumo, los datos de oferta y demanda, los costos de fabricación y los márgenes de beneficio bruto también se examinan en la investigación: los costos de fabricación y los márgenes de beneficio bruto son medidas importantes para anticipar los cambios del mercado. El informe perfila las firmas líderes en la industria Tecnología de biología sintética para proporcionar una mirada profunda al panorama competitivo. En el estudio se puede encontrar información detallada sobre los principales segmentos del mercado y sus perspectivas de crecimiento.
Principales jugadores de la industria involucrados en el mercado Tecnología de biología sintética:
DSM Sinochem Pharmaceuticals, Millipore Sigma, Evolva SA, Thermo Fisher Scientific Inc., E. I. du Pont de Nemours and Company, Synthetic Genomics, Codexis Inc., Integrated DNA Technologies Inc., LC Sciences LLC, Novozymes, Genscript Corporation, Qteros, ATUM, Renewable Energy Group Inc., Synthetic Biologics Inc., Intrexon Corporation, GENEWIZ Inc, Amyris Inc., Green Biologics Ltd.
Obtenga un informe de muestra exclusivo @ www.marketresearchstore.com/sample/synthetic-biology-technology-market-821281
Perspectiva del mercado
- El informe proporciona una descripción general de la industria e identifica los factores clave y las restricciones que influirán en el mercado durante el período de pronóstico.
- El documento ofrece un análisis del análisis FODA y las Cinco Fuerzas de Porter en el mercado global.
- Al pronosticar el crecimiento del mercado Tecnología de biología sintética en la región, el lento crecimiento actual de la economía y el impacto de las iniciativas más recientes del gobierno se han tenido en cuenta a nivel mundial.
- Este estudio analizó los perfiles corporativos de las principales empresas de la industria Tecnología de biología sintética del mundo.
- El estudio se centra específicamente en el desarrollo del mercado Tecnología de biología sintética en China como resultado de la creciente demanda de la región, que ha despertado el interés de los principales fabricantes.
- El estudio examina el panorama de proveedores competitivos de la industria Tecnología de biología sintética global.
- El análisis del atractivo del mercado, el análisis de la viabilidad de la inversión y el análisis del rendimiento de la inversión se utilizan para examinar el mercado global de Tecnología de biología sintética.
Se ha realizado una evaluación exhaustiva de los factores que aceleran y ralentizan el crecimiento del mercado Tecnología de biología sintética, así como de las perspectivas potenciales. El mercado Tecnología de biología sintética se ha examinado en función de las aplicaciones y la distribución regional, y las variables importantes responsables de la creciente demanda del mercado a nivel mundial se han descrito en este estudio. Se han conferido las debilidades y fortalezas fundamentales de los principales proveedores, junto con la tasa de crecimiento para cada uno de los segmentos del mercado global.
Segmentación de mercado
Mercado por tipos:
Ingeniería Genómica, Secuenciación de ADN, Componentes Biológicos y Sistemas Integrados, Otros
Mercado por aplicaciones:
Médico, Industrial, Ambiental, Otros
Explore el informe completo, incluida la tabla de contenido: www.marketresearchstore.com/market-insights/synthetic-biology-technology-market-821281
El mercado Tecnología de biología sintética global se ha fragmentado en varias regiones, como América del Norte, América Latina, Medio Oriente, Asia-Pacífico, África y Europa. Ofrece una instantánea holística del panorama competitivo en todo el mundo para obtener una mejor perspectiva en los negocios.
El mercado Tecnología de biología sintética es único en varios aspectos. La investigación ilumina cada una de estas facetas y profundiza en los distintos segmentos del mercado. La investigación explora el impacto de las numerosas medidas tomadas por el gobierno chino para rehabilitar la economía y cómo afectarán la demanda del mercado Tecnología de biología sintética del país. El documento también analiza los muchos problemas micro y macroeconómicos que afectan al resto de los mercados del mundo. La investigación es un recurso invaluable para las empresas que están considerando invertir en el sector Tecnología de biología sintética.
Para ser valioso para las partes interesadas, un estudio debe incluir una investigación profunda sobre la competitividad del mercado. El informe de investigación perfila las principales empresas clave en el mercado Tecnología de biología sintética para hacer esto. Las principales estrategias empleadas por estas empresas se recopilaron a partir de sus diversos informes financieros y un examen minucioso de la dinámica del mercado que influyó en su curso de acción. El informe analiza minuciosamente los resultados de la estrategia para mantener informadas a las partes interesadas sobre los cambios del mercado. Los hallazgos clave del informe sobre el mercado Tecnología de biología sintética global también ayudarán a los participantes de la industria a descubrir dónde pueden hacer crecer sus negocios.
PREGUNTAS FRECUENTES COMUNES:
- ¿Qué impulsa el crecimiento del mercado Tecnología de biología sintética?
- ¿Cuáles son las últimas Tecnología de biología sintética tendencias del mercado?
- ¿Cómo obtener la muestra del informe de mercado Tecnología de biología sintética?
- ¿De qué manera están creciendo los Tecnología de biología sintética actores del mercado?
- ¿En qué región crecerá el mercado Tecnología de biología sintética en los próximos años?
- ¿Cómo puedo recibir estadísticas sobre los principales Tecnología de biología sintética jugadores del mercado?
- ¿Qué segmento domina el mercado Tecnología de biología sintética?
- ¿Quiénes son los principales accionistas de Tecnología de biología sintética?
- ¿Quiénes son los clientes potenciales de la industria Tecnología de biología sintética?
- ¿Cuánto valdrá Tecnología de biología sintética en 2028?
Tecnología de biología sintética El análisis de mercado es un componente importante de la función de compras y ayuda a crear e implementar estrategias de compras que funcionen para una empresa. Estos datos y puntos de información pueden ayudar a las empresas a cosechar los frutos de la reducción del riesgo y la mejora del éxito empresarial.
Leer más publicación:
Global Concrete And Cement Market Segmentation Cost Structure Industry Size And Shares 2022
Global Cycloidal Gear Reducers Market Size Drivers Restraints Opportunities And Forecast To 2022